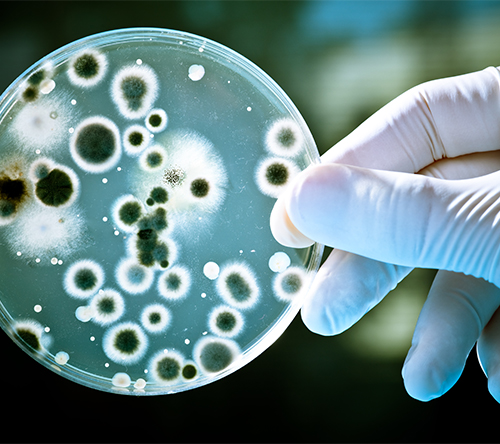
coltura batterica

Cosa sono le zoonosi alimentari, e che differenza c’è con infezioni e intossicazioni?
Le infezioni alimentari sono patologie causate dal consumo di cibo contaminato da agenti patogeni come virus, batteri e muffe. Quando oltre agli agenti vivi e infettivi sono presenti anche le tossine prodotte dal loro metabolismo si parla di tossinfezioni alimentari. Nel caso in cui siano presenti tossine ma i microorganismi che le hanno prodotte siano assenti o morti, si parla di intossicazioni alimentari. Spesso si tratta di zoonosi, cioè di malattie trasmesse in modo diretto o indiretto dagli animali.
Stando ai dati pubblicati da EFSA (Autorità europea per la Sicurezza Alimentare) congiuntamente a ECDC (Centro Europeo per la Prevenzione e il Controllo delle Malattie) nell’ambito del report annuale sulle zoonosi alimentari[1], nel 2018 nella UE sono stati segnalati ben 246.571 casi di infezione da Campylobacter che risulta essere la più frequente. Al secondo posto ci sono i casi di salmonellosi: 91.857. Analizzando i focolai di infezione, ben un terzo sono dovuti a batteri del genere Salmonella.
Vediamo di seguito le più comuni infezioni, come si sviluppano e perche possono rappresentare un problema per l’uomo.
Salmonella
Come abbiamo visto una delle zoonosi più diffuse è sicuramente la salmonellosi. È una malattia causata da vari batteri del genere Salmonella. I sintomi sono febbre, diarrea e crampi addominali. Non è considerata grave ma è molto diffusa, per questo il livello di attenzione deve essere mantenuto alto. Molto frequentemente è dovuta al consumo di uova e prodotti a base di uova, pollame crudo o poco cotto, pesci, crostacei, molluschi, prodotti non pastorizzati.
Per scongiurare il rischio di salmonellosi è necessario cuocere gli alimenti, curare l’igiene di utensili e superfici, refrigerare correttamente i cibi e separare gli alimenti cotti da quelli crudi.
I batteri del genere Salmonella inoltre non tollerano gli ambienti acidi con valore inferiore a 5,5.
Cliccando qui troverai un test facile e veloce per la rilevazione della Salmonella sulle superfici
Listeria Monocytogenes
Il Listeria Monocytogenes è un batterio appartenente alla piu ampia famiglia Listeria ed è responsabile della listeriosi. I sintomi possono variare da quelli più lievi come febbre, nausea e vomito a quelli piu seri come la meningite. È una malattia grave che nel 13.2% dei casi puo condurre alla morte[2] ed ha elevati tassi di ricovero ospedaliero. Fortunatamente è abbastanza rara, nel 2018 nell’Unione Europea ne sono stati registrati 2.549 casi.
Il batterio Listeria vive nel terreno, nelle acque e nelle piante, ma possono esserne vettori anche gli animali come ovini, caprini e bovini. La principale via di trasmissione è il consumo di cibo o di mangime contaminato, ma si può diffondere anche attraverso il contatto con esemplari infetti.
Per eliminare il rischio di Listeria bisogna cuocere il cibo a temperature superiori ai 65° e prediligere i cibi pastorizzati (oltre ovviamente a seguire le buone norme di igiene e corretta manipolazione del cibo).
È necessario prestare attenzione ai cibi pronti che non vengono cioè ricotti ma solo scaldati. E’importante inoltre ricordare che questo batterio resiste in ambienti salati e tollera le basse temperature e gli ambienti alcalini, in quelli acidi invece resiste ma non si moltiplica.
Cliccando qui troverai un pratico test monouso per la rilevazione della Listeria sulle superfici
Escherichia coli
Si tratta di un batterio piuttosto comune nell’intestino umano e in quello animale che in genere non provoca danni. Esistono ceppi innocui di Escherichia coli, utili in quanto partecipano alla sintesi della vitamina K; altri invece possono causare diarrea più o meno grave. La gravità della patologia è determinata dal tipo di ceppo: in alcuni casi si ha la presenza di tossine aggressive e dannose che possono causare diarrea sanguinolenta, crampi intestinali ed altre complicanze anche gravi. La contaminazione in genere avviene ingerendo acqua o cibi contaminati come la carne di bovino poco cotta, ortaggi crudi, prodotti non pastorizzati.
Campylobacter
Sono principalmente 4 le specie appartenenti al genere Campylobacter che provocano malattie nell’uomo: Campylobacter jeujini, Campylobacter coli, Campylobacter lari e Campylobacter fetus. I primi tre sono i più diffusi e provocano gastroenteriti. Il quarto invece provoca infezioni in particolare ai neonati o a soggetti immunodepressi. I sintomi sono diarrea, dolore addominale, febbre e mal di testa e sono causati soprattutto dalle enterotossine prodotte dal batterio. Si tratta di una zoonosi molto diffusa in tutto il mondo, anche nei paesi industrializzati. Il contagio generalmente avviene tramite l’ingestione di alimenti contaminati da feci di animali infetti. La carne poco cotta, soprattutto quella di pollo o la carne macinata, e i prodotti non pastorizzati sono il principale veicolo di infezione. Fortunatamente questi batteri hanno una scarsa resistenza sulle superfici, per questo gli utensili in genere non rappresentano un veicolo di infezione.
Yersinia Enterocolitica
Si tratta di un batterio che può causare gastroenterite accompagnata da febbre e dolori addominali, dopo un periodo di incubazione di 4 – 7 giorni. Come per altre zoonosi, il contagio è da imputarsi all’ingestione di acqua o alimenti contaminati da feci di animali infetti o da cibi crudi o poco cotti. Questo batterio resiste alle basse temperature, tanto da potersi sviluppare anche nei cibi refrigerati.
| BATTERIO | PATOLOGIA | SINTOMI PRINCIPALI | ALIMENTI VETTORE | PREVENZIONE |
| Salmonella | Salmonellosi | Febbre, diarrea, crampi addominali. | Uova, carne cruda di suini, tacchini e polli, pesci, crostacei, molluschi, prodotti non pastorizzati. | Corretta manipolazione e conservazione del cibo, cottura, separazione di cibo cotto e crudo. |
| Listeria Monocytogenes | Listeriosi | Vomito, diarrea, meningite. | Pesce affumicato, carne, formaggi, ortaggi crudi, cibi pronti. | Cottura oltre i 65°C, pastorizzazione. |
| Escherichia coli | Diverse patologie | Diarrea, dolori addominali. | Carne di manzo poco cotta, ortaggi crudi, prodotti non pastorizzati. | Cottura oltre i 70°C. |
| Campylobacter | Campylobacteriosi | Vomito, diarrea, febbre. | Carne cruda o poco cotta, alimenti non pastorizzati | Cottura, pastorizzazione. |
| Yersinia | Yersiniosi | Vomito, diarrea, dolori addominali. | Carne cruda o poco cotta, ostriche, latte crudo. | Cottura oltre i 60°C. |
Per prevenire le infezioni alimentari è fondamentale seguire alcune buone regole:
- Lavarsi le mani
- Separare alimenti cotti e crudi evitando la contaminazione crociata
- Prediligere alimenti pastorizzati e cotti
- Cuocere adeguatamente i cibi
- Curare l’igiene di utensili e superfici
- Conservare correttamente il cibo
- Lavare accuratamente frutta e verdura prima del consumo
[1] “The European Union One Health 2018 Zoonoses Report” European Food Safety Authority and European Centre for Desease Prevention and Control (EFSA and ECDC)
[2] Dati EFSA riferiti all’anno 2018 nell’Unione Europea